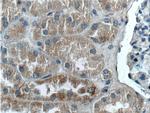
ZRANB3 Antibody in Immunohistochemistry (Paraffin) (IHC (P))
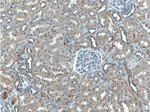
ZRANB3 Antibody in Immunohistochemistry (Paraffin) (IHC (P))

Search
Proteintech
ZRANB3 Polyclonal Antibody
{{$productOrderCtrl.translations['antibody.pdp.commerceCard.promotion.promotions']}}
{{$productOrderCtrl.translations['antibody.pdp.commerceCard.promotion.viewpromo']}}
{{$productOrderCtrl.translations['antibody.pdp.commerceCard.promotion.promocode']}}: {{promo.promoCode}} {{promo.promoTitle}} {{promo.promoDescription}}. {{$productOrderCtrl.translations['antibody.pdp.commerceCard.promotion.learnmore']}}
产品信息
23111-1-AP
种属反应
已发表种属
宿主/亚型
分类
类型
抗原
偶联物
形式
浓度
规格
纯化类型
保存液
内含物
保存条件
运输条件
产品详细信息
Immunogen sequence: LPVYDTLMF CASRNTDRIH IYTKDGKQMS CNFIPLDIKL DLWEDLPASF QLKQYRSLIL RFVREWSSLT AMKQRIIRKS GQLFCSPILA LEEITKQQTK QNCTKRYITK EDVAVASMDK VKNVGGHVRL ITKESRPRDP FTKKLLEDGA CVPFLNPYTV QADLTVKPST SKGYLQAVDN EGNPLCLRCQ QPTCQTKQAC KANSWDSRFC SLKCQEEFWI RSNNSYLRAK VFETEHGVCQ LCNVNAQELF LRLRDAPKSQ RKNLLYATWT SKLPLEQLNE MIRNPGEGHF WQVDHIKPVY GGGGQCSLDN LQTLCTVCHK ERTARQAKER SQVRRQSLAS KHGSDITRFL VKK (728-1079 aa encoded by B C064616)
靶标信息
DNA annealing helicase and endonuclease required to maintain genome stability at stalled or collapsed replication forks by facilitating fork restart and limiting inappropriate recombination that could occur during template switching events (PubMed:21078962, PubMed:22704558, PubMed:22705370, PubMed:22759634, PubMed:26884333). Recruited to the sites of stalled DNA replication by polyubiquitinated PCNA and acts as a structure-specific endonuclease that cleaves the replication fork D-loop intermediate, generating an accessible 3'-OH group in the template of the leading strand, which is amenable to extension by DNA polymerase (PubMed:22759634). In addition to endonuclease activity, also catalyzes the fork regression via annealing helicase activity in order to prevent disintegration of the replication fork and the formation of double-strand breaks (PubMed:22705370, PubMed:22704558). [UniProt]
仅用于科研。不用于诊断过程。未经明确授权不得转售。
生物信息学
蛋白别名: AH2; Annealing helicase 2; DNA annealing helicase and endonuclease ZRANB3; unnamed protein product; Zinc finger Ran-binding domain-containing protein 3; zinc finger, RAN-binding domain containing 3
基因别名: 4933425L19Rik; AH2; ZRANB3
UniProt ID: (Human) Q5FWF4
Entrez Gene ID: (Human) 84083